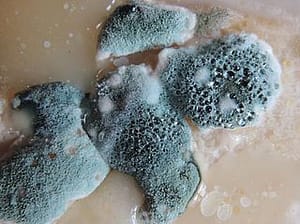
molds in your home

Condo Living Fatigue: Why Some Buyers Are Moving Back to Houses
Condominium living once symbolized convenience and modern urban life. Buyers were drawn to security, amenities, and low-maintenance ownership. For many, condos offered proximity to work, restaurants, and entertainment. Over time, however, some owners began to feel a different reality. Shared walls, limited space, and rising association fees created tension. As lifestyles shifted, especially with remote work becoming more common, a growing number of buyers started reconsidering their choices. Condo living fatigue is not universal, but it explains why some residents are moving back to single-family houses.
The Strain of Limited Space

Space matters more than many buyers initially expect. Condos often maximize layout efficiency, but square footage remains constrained. When residents begin working from home, hosting family, or pursuing hobbies, limitations become clear. A small balcony cannot replace a backyard. A compact second bedroom may struggle to function as both an office and a guest space. Over time, a lack of expansion options creates frustration. Houses offer flexibility. Garages, attics, and basements provide room to adapt. This flexibility helps ensure long-term comfort as needs evolve.
Noise and Shared Boundaries
Living in close proximity to neighbors has benefits. It also has challenges. Noise from adjacent units, hallways, or shared amenities can disrupt daily life. While some buildings maintain strong sound insulation, others do not. Repeated disturbances may lead to stress. Privacy also feels reduced in high-density environments. Shared elevators and common spaces increase interaction frequency. For buyers seeking greater quiet and autonomy, detached homes provide relief from constant proximity.
Lifestyle Changes After Remote Work

Remote work reshaped housing priorities. Proximity to downtown offices became less critical. Commute times lost urgency. Buyers began valuing home offices, outdoor space, and storage more highly. Houses often provide these features more easily. Condos excel in walkability and shared amenities. However, when daily routines shift indoors, space and privacy gain importance. Lifestyle evolution influences housing choices. Flexibility often drives relocation decisions.
Assessments and Rising Association Fees
Condo ownership includes homeowners’ association fees. These cover maintenance, amenities, and building management. Initially, these fees seem manageable. Over time, they may increase. Special assessments for repairs or upgrades add financial pressure. Owners sometimes feel limited control over these decisions. Board policies influence costs and regulations. Houses require maintenance as well, but expenses feel more directly managed. Some buyers prefer controlling their own repair schedules and budgets.
Community Dynamics and Rules

Condo living involves shared governance. Rules regulate renovations, pets, parking, and exterior changes. These policies protect collective property value. They can also feel restrictive. Homeowners accustomed to greater autonomy may grow fatigued by approval processes. The desire to personalize property freely influences movement back to houses. Community engagement remains important, but personal control appeals strongly to certain buyers.
The Appeal of Long-Term Stability
Single-family homes often provide perceived stability. Land ownership carries symbolic and practical value. Appreciation patterns may differ between houses and condos depending on market conditions. Some buyers view houses as longer-term assets. Outdoor space, expansion potential, and reduced shared dependency contribute to the appeal. Condo living continues to suit many individuals. However, those seeking space, autonomy, and flexibility increasingly look toward detached properties.
Condo living fatigue arises from limited space, shared noise, rising association fees, evolving work patterns, and governance restrictions. As lifestyles change, some buyers prioritize privacy, autonomy, and flexibility over urban convenience. Single-family houses offer expansion potential and greater control over maintenance decisions. While condos remain attractive for many, shifting preferences explain why some residents choose to return to traditional homes.…
Unusual Plants That Make Your Landscape Stand Out From the Crowd
Creating a landscape that truly stands apart requires more than planting the usual shrubs and flowers. For gardeners and homeowners looking to make a statement, incorporating unusual plants adds visual interest, texture, and color that are difficult to find in conventional landscaping choices. These plants possess intriguing shapes, bold hues, and sometimes unexpected functions that draw attention and invite curiosity. Selecting such species enables an outdoor space that reflects personality and creativity while also providing a dynamic and refreshing garden atmosphere. Exploring some of these exceptional plants can inspire ideas for transforming ordinary yards into extraordinary retreats.
Blue Agave
The Blue Agave is a succulent plant famous for its striking rosette of broad, spiky leaves in a cool blue-gray tone. Native to arid regions, this plant is exceptionally drought-tolerant and thrives under full sun, making it perfect for xeriscaping or desert-themed gardens. Its architectural form adds a sculptural quality to landscapes and naturally becomes a focal point due to its dramatic presence. The Blue Agave can grow quite large over time, offering a bold visual anchor in garden beds or rock gardens.

Japanese Blood Grass
Adding a splash of vivid color to green spaces, Japanese Blood Grass stands out with its slender blades that shift to bright crimson in late summer and fall. This ornamental grass grows in clumps, adding height and movement with its fine texture. Unlike traditional lawn grasses, it does not spread aggressively, which makes it easy to manage in garden borders or mixed planting beds. The rich red tones create striking contrast with other plants, especially those with variegated or silvery foliage.
Variegated Elephant Ear
For a tropical vibe, the Variegated Elephant Ear is an excellent choice. Known for its oversized heart-shaped leaves that feature a blend of green and creamy white variegation, this plant introduces bold foliage that instantly grabs attention. It prefers shaded or partially sunny areas and thrives in moist, fertile soil. Its large leaves provide excellent coverage and add depth to the garden’s layers. This plant’s dramatic size and patterning make it an eye-catching alternative to traditional greenery.
Bat Flower
One of the most unusual flowering plants is the Bat Flower. Named for its dark, wing-shaped petals that resemble a bat in flight, this exotic plant blooms with almost black flowers accented by long tendrils. It is native to tropical forests and prefers warm, humid environments with filtered sunlight. The Bat Flower’s unique shape and color contrast starkly with more common garden blooms, making it a perfect conversation starter and a dramatic addition to shaded garden corners.

Pitcher Plants
Pitcher Plants offer an intriguing blend of beauty and function. These carnivorous plants have tubular, pitcher-shaped leaves designed to trap insects, which they use as a nutrient source in poor soil conditions. They thrive in moist, bog-like environments and lend a whimsical and somewhat mysterious air to garden areas that mimic wetlands or damp conditions. The colorful pitchers often feature patterns and vibrant tones that add both texture and interest to a landscape, appealing to gardeners fascinated by unusual plant adaptations.
Conclusion
Incorporating unusual plants into landscaping is an effective way to create a garden that stands out with character and flair. The Blue Agave’s bold form, Japanese Blood Grass’s fiery hues, the Variegated Elephant Ear’s tropical foliage, the mysterious Bat Flower, and the functional elegance of Pitcher Plants all provide distinctive elements that conventional gardens rarely display. Choosing such plants not only enhances the aesthetic appeal but also reflects a gardener’s adventurous spirit and appreciation for the diversity of nature. By blending these exceptional species thoughtfully, any outdoor space can become a unique showcase that captivates visitors and brings endless enjoyment.…
Cut down on Cooking Time With These Must-Have Kitchen Appliances
Are you tired of spending hours in the kitchen every day, slaving away over a hot stove? Say goodbye to long cooking times and hello to convenience with these must-have kitchen appliances. Whether you’re a busy parent, a working professional, or just looking to streamline your meal prep routine, these tools will help you cut down on cooking time and make delicious meals in no time. Get ready to revolutionize your kitchen and reclaim your time with these game-changing gadgets.
Instant Pot

The Instant Pot has become a kitchen staple for many households thanks to its versatility and convenience. This multi-functional appliance combines the functions of a pressure cooker, slow cooker, rice cooker, steamer, sauté pan, and yogurt maker in one compact device. With the Instant Pot, you can cook a wide variety of dishes—from soups and stews to risottos and desserts—in a fraction of the time it would take using traditional cooking methods.
Air Fryer
If you crave the crispy texture of fried foods without guilt, the melhor airfryer 2024 is the perfect solution. Using hot air circulation, air fryers crisp up food using significantly less oil than traditional frying methods. From French fries to chicken wings, you can enjoy your favorite indulgences with less fat and fewer calories, all while saving time in the kitchen. With this appliance, you can enjoy the taste and texture of fried foods without the added health risks.
Food Processor
Say goodbye to endless chopping and slicing with a high-quality food processor. From chopping vegetables to mixing dough, a food processor can handle a wide range of kitchen tasks with ease. With attachments for shredding, slicing, and grating, this versatile appliance is a true time-saver for any home cook.
Blender

Whether you’re whipping up smoothies, soups, or sauces, a powerful blender is a must-have kitchen appliance. Look for a blender with multiple speed settings and a durable motor to ensure smooth and consistent results every time. With the ability to quickly puree ingredients, a blender can help you create delicious dishes in minutes.
Stand Mixer
Baking enthusiasts rejoice – a stand mixer can make your life infinitely easier. From mixing batter to kneading dough, a stand mixer can handle tough tasks with ease, saving you time and effort in the kitchen. With a variety of attachments available, including dough hooks and wire whisks, a stand mixer is a versatile tool that can tackle a wide range of recipes.
Programmable Coffee Maker
For many of us, coffee is the fuel that powers our mornings. A programmable coffee maker allows you to wake up to the aroma of freshly brewed coffee, ready and waiting to kickstart your day. With features like auto-brew timers and adjustable brew strength settings, you can customize your coffee to suit your taste preferences, all while saving valuable time in the morning rush.
In conclusion, investing in time-saving kitchen appliances can greatly simplify your life and enhance your culinary experience. Whether you’re looking to cut down on cooking time, streamline meal prep, or expand your culinary repertoire, these essential appliances are sure to become invaluable tools in your kitchen arsenal. By incorporating these appliances into your daily routine, you can reclaim precious time and enjoy delicious meals with minimal effort.…
The Benefits of Hiring a Professional Pest Extermination Service for Your Home
Are creepy crawlies and unwanted pests making themselves at home in your living space? Don’t let these uninvited guests take over – it’s time to call in the professionals. In this blog post, we’ll explore the many benefits of hiring a professional pest extermination service for your home. From saving you time and money to ensuring a safe and effective removal process, discover why leaving it to the experts is the best way to say goodbye to those pesky pests for good.
Expertise and Experience
One of the biggest reasons to hire a professional pest extermination service is for their expertise and experience. Pest control professionals undergo rigorous training and certification to become licensed exterminators, equipping them with the knowledge and skills needed to identify, treat, and prevent pest infestations effectively.
They understand the behavior and biology of common household pests, allowing them to develop customized treatment plans tailored to your specific needs. With Top Bed Bug Removal Expert, you can expect a high level of expertise and experience when it comes to dealing with pest problems.
Customized Treatment Plans

Speaking of customized treatment plans, professional pest exterminators can tailor their services to address your unique pest problems. Whether you’re dealing with ants in the kitchen, termites in the walls, or bed bugs in the bedroom, pest control professionals can develop a targeted treatment plan that effectively eliminates the pests while minimizing risks to you, your family, and your pets.
Safe and Effective Methods
When it comes to pest control, safety is paramount – for you, your loved ones, and the environment. Professional pest extermination services use safe and effective methods to eradicate pests from your home, including environmentally friendly options that minimize harm to non-target organisms. From baits and traps to pesticides and insecticides, pest control professionals have access to a wide range of tools and techniques to get the job done right.
Long-Term Solutions

While DIY methods may temporarily relieve pests, they often fail to address the underlying causes of infestations, leading to recurring problems down the road. Professional pest extermination services eliminate not only existing pests but also implement long-term solutions to prevent future infestations. They can identify and seal entry points, remove attractants such as food and water sources, and provide ongoing monitoring and maintenance to keep pests at bay for good.
Time and Convenience
Let’s face it – dealing with a pest infestation can be time-consuming and inconvenient, especially if you’re trying to juggle work, family, and other responsibilities. Hiring a professional pest extermination service allows you to save time and hassle by outsourcing the job to experts who can get the job done quickly and efficiently. Plus, you won’t have to worry about sourcing and storing pesticides or dealing with the cleanup afterward – it’s all taken care of for you.
Peace of Mind

Last but not least, hiring a professional pest extermination service provides peace of mind, knowing that your home is pest-free and your family is safe from harm. You can rest easy knowing that trained professionals have thoroughly inspected your home, treated any existing infestations, and implemented measures to prevent future problems. With the help of professional pest control, you can enjoy a clean, healthy, and pest-free living environment for years to come.
So there you have it – six compelling reasons why every homeowner should hire a professional pest extermination service. From their expertise and experience to their customized treatment plans and long-term solutions, pest control professionals have the knowledge, tools, and techniques needed to effectively eliminate pests from your home and keep them at bay for good. So don’t let pests take over your home – enlist the help of professionals and reclaim your space today.…
Good Tips to Repair Your Landscape After a Fire
Today, we’re going to tackle a topic that many homeowners dread but are unfortunately all too familiar with: repairing your landscape after a fire. Though some people often choose to sell their property after a fire, such as explained in the article “Selling A House With Fire Damage,” you can still bring your landscape back to life. Whether you’ve recently experienced a wildfire or had a smaller incident in your backyard, the aftermath can surely be devastating. But fear not. We’ve got some good tips to help you restore and rejuvenate your outdoor space.
Focus on Erosion Control
The intense heat from the flames can often leave the soil very much exposed and vulnerable to erosion, especially during heavy rains or strong winds. To prevent further damage, start by assessing the areas that are at high risk for erosion. These may include steep slopes or areas with loose soil. Consider using erosion control blankets or mats made from biodegradable materials like straw or coconut fiber. These blankets help stabilize the soil while allowing water and air to penetrate. Another effective method is planting groundcover plants such as grasses, shrubs, or native wildflowers in bare areas. Their root systems will help bind the soil together and reduce erosion risk.
Repair Damaged Soil
The intense heat can also cause significant damage to the soil structure as well as the soil’s ability to hold water. So, it’s your call to take the necessary actions to rejuvenate your soil. To begin with, remove any debris or ash that may be covering the ground so that you can assess the condition of the soil underneath. If you notice that it has become compacted or hardened due to extreme temperatures, you might need to loosen it up using a garden fork or tiller.
After loosening up the soil, consider adding organic matter such as compost or well-rotted manure. These additions will help improve nutrient levels and enhance moisture retention capacity in the soil. In addition, consider conducting a soil test before replanting in order to determine if any specific nutrients are lacking. Based on these results, you can choose appropriate fertilizers or amendments that will replenish those nutrients and promote healthy plant growth.

Do Some Replanting and Reseeding
Replanting and reseeding are crucial steps in repairing your landscape after a fire. These processes help to restore the natural beauty of your surroundings and promote regrowth. Before planting, make sure you prepare the soil properly. Clear away any debris or ash, as these can hinder plant growth. Once you’ve prepared the soil, carefully select where each plant should go based on its light requirements and spacing recommendations. Be mindful of creating diversity in your landscaping design by incorporating different heights, textures, and colors. In addition to replanting existing areas, consider reseeding bare patches or areas where vegetation was completely destroyed by the fire. Choose the appropriate grass seed for your region and follow instructions for proper seeding techniques.
Practice Firescaping Principles for Preventive Measures
When it comes to repairing your landscape after a fire, prevention is key. One of the best ways to prevent future damage is by practicing firescaping principles. Firescaping involves designing and maintaining your outdoor spaces in a way that reduces the risk of fire spreading. One important principle of firescaping is creating defensible space around your home. This means clearing away any flammable materials, such as dead plants or debris, within a certain radius of your house. By doing this, you create a buffer zone that can help protect your property from an approaching fire.
Remember that nature has incredible resilience; even in the face of adversity like wildfire devastation, it has the ability to regenerate itself over time. Embrace this process as an opportunity for renewal and see it as a testament to the strength of Mother Nature herself.…
Importance of Getting Your Sewer Line Checked
Today, we’re going to dive into a topic that may not be the most glamorous or exciting but is undeniably important for homeowners – getting your sewer line checked. Now, before you click away, thinking this isn’t relevant to you, hold on just a moment. Did you know that neglecting your sewer line could lead to costly repairs, health hazards, and even impact the value of your home? That’s right; it’s time to shine a spotlight on this often-forgotten aspect of home maintenance. So stick around as we explore why checking your sewer line should be at the top of every homeowner’s priority list. Trust us; it’s worth it.
Preventing Blockages
 Nobody likes dealing with a blocked sewer line. It’s messy, inconvenient, and can cause major headaches for homeowners. However, the good news is that regular checks and maintenance can help prevent these blockages from occurring in the first place. One of the main culprits behind sewer blockages is debris buildup. Over time, items like grease, hair, food particles, and even tree roots can accumulate in your pipes and create obstructions. By getting your sewer line checked regularly by a professional plumber, you can identify any potential issues before they turn into full-blown clogs. If you think that your sewer line is blocked, consider hiring the sewer line cleaning philadelphia.
Nobody likes dealing with a blocked sewer line. It’s messy, inconvenient, and can cause major headaches for homeowners. However, the good news is that regular checks and maintenance can help prevent these blockages from occurring in the first place. One of the main culprits behind sewer blockages is debris buildup. Over time, items like grease, hair, food particles, and even tree roots can accumulate in your pipes and create obstructions. By getting your sewer line checked regularly by a professional plumber, you can identify any potential issues before they turn into full-blown clogs. If you think that your sewer line is blocked, consider hiring the sewer line cleaning philadelphia.
Avoiding Costly Repairs
When it comes to your sewer line, one thing is for certain: neglecting it can lead to costly repairs down the line. Many homeowners underestimate the importance of regular inspections and maintenance for their sewer lines, but the truth is that a small issue today can quickly turn into a major problem tomorrow. One of the main reasons why getting your sewer line checked regularly is important is because it helps prevent small problems from turning into big ones. Over time, debris and sediment can build up in your pipes, causing blockages that restrict the flow of wastewater. If left unchecked, these blockages can ultimately lead to sewage backups in your home or yard – a messy and expensive ordeal to clean up. In addition to preventing blockages, regular sewer line checks also help identify any potential leaks or cracks in the pipes.
Protecting Your Health
When it comes to the maintenance of your home, there’s one aspect that often gets overlooked: the sewer line. While it may not be the most glamorous topic, taking care of your sewer line is crucial for protecting your health. A damaged or clogged sewer line can lead to a host of health issues. For starters, sewage backup can result in foul odors and unsanitary conditions in and around your home. This can attract pests like rats and insects that carry diseases. Furthermore, sewage contains harmful bacteria and pathogens that can pose serious health risks if you come into contact with them. Exposure to these contaminants can lead to infections, gastrointestinal problems, respiratory issues, and other illnesses.
Maintaining Home Value
 When it comes to maintaining the value of your home, there are several factors to consider. One often overlooked aspect is the condition of your sewer line. While it may not be the most glamorous topic, a well-maintained sewer line can have a significant impact on your property’s overall value. First and foremost, regular inspections and maintenance of your sewer line can help prevent any potential issues from escalating into costly repairs down the line. By catching small problems early on, you can save yourself from major headaches and expenses in the future.
When it comes to maintaining the value of your home, there are several factors to consider. One often overlooked aspect is the condition of your sewer line. While it may not be the most glamorous topic, a well-maintained sewer line can have a significant impact on your property’s overall value. First and foremost, regular inspections and maintenance of your sewer line can help prevent any potential issues from escalating into costly repairs down the line. By catching small problems early on, you can save yourself from major headaches and expenses in the future.
Furthermore, a properly functioning sewer system is crucial for potential buyers who are considering purchasing your home. A faulty or outdated sewer line can be a major red flag during an inspection and could lead to negotiations or even scare away potential buyers altogether. Please don’t wait until it’s too late. Contact a professional plumber today to schedule a thorough inspection of your sewer line. This proactive approach will save you from future headaches and expenses while ensuring …
Signs Your Kitchen Cabinet Needs Replacement
Is your kitchen cabinet in need of a makeover? Over time, our cabinets can take quite a beating. From daily wear and tear to accumulating damage that goes beyond quick fixes, it’s more than important to know when it’s time for either going for replacing vs new cabinets.
But how do you really tell if your kitchen cabinet is on its last legs? Today, we’ll uncover the surefire ways to determine if your cabinets are in desperate need of an upgrade.
Multiple Cracks and Damages Beyond Fixes
 The first sign that your kitchen cabinet is in dire need of replacement is when you start noticing multiple cracks and damages beyond simple fixes. Maybe there’s a crack running down the center, or perhaps the edges are chipped and peeling. Whatever the case may be, these visible signs of wear and tear can not only be unsightly but also compromise the functionality of your cabinets. When cracks begin to appear, it’s often an indication that the structural integrity has been compromised. This means that even if you try to patch up those tiny fractures, they will likely reappear sooner rather than later. And let’s face it, no one wants their dishware precariously balanced on a cracked shelf.
The first sign that your kitchen cabinet is in dire need of replacement is when you start noticing multiple cracks and damages beyond simple fixes. Maybe there’s a crack running down the center, or perhaps the edges are chipped and peeling. Whatever the case may be, these visible signs of wear and tear can not only be unsightly but also compromise the functionality of your cabinets. When cracks begin to appear, it’s often an indication that the structural integrity has been compromised. This means that even if you try to patch up those tiny fractures, they will likely reappear sooner rather than later. And let’s face it, no one wants their dishware precariously balanced on a cracked shelf.
Aging Poorly
Over time, cabinets can start to show signs of wear and tear that are simply beyond repair. One common issue with aging cabinets is peeling or cracking paint or veneer. This not only looks unsightly but also leaves the underlying wood exposed to moisture and potential damage. Another sign of aging cabinets is loose or broken hinges and handles. If you find yourself constantly tightening screws or struggling to open and close your cabinet doors, it may be time for a replacement. Aging cabinets can also have warped or sagging shelves, making it difficult to store items properly.
Safety Being Compromised
When it comes to your kitchen, safety should always be a top priority. Your cabinets play a crucial role in maintaining a safe environment, as they store sharp objects and heavy items that can pose potential dangers if not properly secured. So, how do you know when your cabinets are compromising safety? One clear sign is if the doors or drawers are constantly falling off or becoming loose. Another red flag is if you notice any structural issues with the cabinets themselves. For example, if you see cracks in the wood or signs of warping, this could indicate that the cabinet is no longer sturdy enough to hold its contents securely.
Severe Mold and Mildew Growth
 These fungi thrive in moist environments, making your cabinets a perfect breeding ground for them. When you see black or green patches on the surface of your cabinets, it’s a clear indication that mold and mildew have taken hold. Not only are they unsightly, but they can also pose serious threats to you and your family. Breathing in mold spores can put you at a great risk of suffering from respiratory problems, allergies, and even infections. Mold and mildew growth typically occurs when there is excessive moisture in your kitchen. Cleaning off visible mold may provide temporary relief, but if the problem persists or keeps coming back despite regular cleaning efforts, it’s time to consider replacing your cabinets entirely.
These fungi thrive in moist environments, making your cabinets a perfect breeding ground for them. When you see black or green patches on the surface of your cabinets, it’s a clear indication that mold and mildew have taken hold. Not only are they unsightly, but they can also pose serious threats to you and your family. Breathing in mold spores can put you at a great risk of suffering from respiratory problems, allergies, and even infections. Mold and mildew growth typically occurs when there is excessive moisture in your kitchen. Cleaning off visible mold may provide temporary relief, but if the problem persists or keeps coming back despite regular cleaning efforts, it’s time to consider replacing your cabinets entirely.
This is because the mold could have penetrated deep into the wood structure of the cabinet, making it difficult to eradicate completely. At the end of the day, a well-functioning kitchen is the heart of any home. Don’t overlook the signs that your cabinets may be past their prime. Consider these surefire ways to tell if your kitchen cabinet needs replacement and take action to upgrade your space accordingly. With fresh new cabinets in place, you’ll not only enhance the overall look of your kitchen but also improve its efficiency and safety.…
Tips on Choosing a Dining Table for Your Home
When it comes to choosing a dining table for your home, there are many factors to consider. Size, shape, and style are all important considerations, but perhaps the most critical factor is the type of material the table is made from. There are many different materials to choose from, each with its own advantages and disadvantages. Here, we will talk about tips on choosing a dining table for your home.
Consider the Material
One tip when choosing a dining table is to consider the material it is made from. Different materials offer different advantages, so it’s important to weigh your options carefully. Many homeowners prefer natural materials, wood. If you plan on buying wooden tables for your dining area, you should check out different styles. This way, you can choose which style is ideal to be placed in your home. Glass is another popular material for dining tables. It can make any space look more modern and elegant. However, glass tables require extra care since they are prone to scratches and chips.
Consider the Shape
Another tip on choosing a dining table is to consider the shape. Round and rectangular tables are the most popular shapes, but there are also oval and square options available. It’s essential to consider the space you have in your dining area when making this decision. If you have limited space, round ones are ideal. On the other hand, if you have more space and want to create an impressive dining area, a rectangular or square table is better. This is usually the preferred option for larger dining rooms. Large families may also prefer rectangular tables since they provide more seating.
Measure the Space

The last tip when choosing a dining table is to measure the space you have in your dining area. This will help you determine the size and shape of the table you need in order to fit comfortably. If your dining area is small, choosing a round or square table might be best. For larger spaces, an oval or rectangular table may be more suitable. Additionally, you should take into account the number of people who will be using the table. This way, you can make sure it is large enough to accommodate everyone comfortably.
When choosing the perfect dining table for your home, you will want to consider a few things. By keeping these tips in mind, you can be sure to select a table that perfectly suits your needs and style. So, what are you waiting for? Start shopping for the perfect dining table today. We hope that you have found this blog post helpful.…
Biggest Bedroom Arrangement Mistakes to Avoid
Your bedroom is your personal sanctuary. A place where you can relax on warm bamboo doona cover sets and unwind after a long day. It’s crucial to ensure that your bedroom is arranged in a way that makes you feel relaxed. Unfortunately, many people make common mistakes when setting up their bedrooms. To help you avoid making these mistakes, we’ve compiled a list of the five biggest bedroom arrangement mistakes and how to avoid them.
Bed Placement
 One of the most common bedroom arrangement mistakes is placing your bed against the wall. While this may seem logical for your bed, it can make your room feel smaller and more cramped. Instead, try placing your bed in the middle of the room. It will make your room feel more open and spacious.
One of the most common bedroom arrangement mistakes is placing your bed against the wall. While this may seem logical for your bed, it can make your room feel smaller and more cramped. Instead, try placing your bed in the middle of the room. It will make your room feel more open and spacious.
Placing your bed too close to the door is also a mistake. It can make you feel vulnerable while you’re trying to sleep. Instead, try placing your bed against a different wall or in the room’s corner. It’ll give you a sense of privacy and security.
Furniture Placement
Another mistake people make when arranging their bedrooms is placing their furniture against the walls. While this may seem like the logical thing to do, it can make your room feel smaller and more cramped. Instead, try arranging your furniture to create an open floor plan. It will make your room feel larger and more spacious.
Clutter
Don’t forget to declutter. Clutter can make your room feel small and cramped and can also be a source of stress. To avoid this mistake, declutter your bedroom regularly. It will help you keep your space tidy and organized, and it will also help you relax and feel more at peace. You can hire a professional organizer to help you declutter your bedroom if you lack the time.
Keeping too Many Plants
While plants can help purify the air in your bedroom and make it feel more inviting, keeping too many plants can negatively impact your health. Plants release carbon dioxide at night, which can cause respiratory problems. If you’re going to keep plants in your bedroom, limit yourself to a few small ones.
Poor Lighting
 Many people make the mistake of using harsh overhead lighting in their bedrooms. While this may be fine for other rooms in your house, it can be detrimental to your sleep. Instead, try using softer and more diffused lighting to create a calming and relaxing environment. You can also use lamps to create different lighting effects in your room.
Many people make the mistake of using harsh overhead lighting in their bedrooms. While this may be fine for other rooms in your house, it can be detrimental to your sleep. Instead, try using softer and more diffused lighting to create a calming and relaxing environment. You can also use lamps to create different lighting effects in your room.
Conclusion
By avoiding these common mistakes, you can create a beautiful and relaxing bedroom where you’ll love spending time. Just remember to keep your space uncluttered, use soft lighting, and place your furniture in a way that creates an open floor plan. You can transform your bedroom into a haven of peace and tranquility with a little effort.…
How to Boost Home Value
There are many things you can do to boost the value of your home. One is by purchasing butcher blocks for restaurants rather than the common countertops for homes. Many homeowners think that installing high-end countertops increases the value of their home. Butcher blocks can be a unique touch to your kitchen. They also have the added benefit of being very easy to clean. Here, we will talk about how you can boost home value.
Maintain Your Lawn
Maintaining your lawn is one of the most important things you can do to increase your home value. A well-manicured lawn shows that you take pride in your home and helps create curb appeal. Curb appeal is important because it is the first thing potential buyers see when they drive up to your house. If your yard looks unkempt, it will turn potential buyers away. Studies have shown that homes with well-maintained lawns sell for up to 17% more than homes without a lawn.
Update The Hardware
If your home’s door knobs, light fixtures, and other hardware are outdated, it can make the house look dated. Replacing these items is a relatively inexpensive way to give your home an updated look. You can find new hardware at any home improvement store. You can also find hardware at second-hand stores or online if you want to save money. This is how many homeowners can find unique hardware for their homes.
Install Energy-Efficient Windows
 Installing energy-efficient windows is a great way to save money on your energy bills and make your home more attractive to buyers. These windows are also good for the environment, which is a bonus. Energy-efficient windows come in various styles, so you can find ones that match the style of your home. Many of these windows also come with a warranty, which is another selling point for potential buyers. So, whether you’re getting ready to put your home on the market or are just curious about how you could increase its value, consider these ideas.
Installing energy-efficient windows is a great way to save money on your energy bills and make your home more attractive to buyers. These windows are also good for the environment, which is a bonus. Energy-efficient windows come in various styles, so you can find ones that match the style of your home. Many of these windows also come with a warranty, which is another selling point for potential buyers. So, whether you’re getting ready to put your home on the market or are just curious about how you could increase its value, consider these ideas.
You might be surprised at how much of a difference even a small change can make in the overall worth of your home. And who knows? Applying some of these tips may help boost your home’s value enough that you won’t have to move after all. Have any questions about increasing your home’s value? Shoot us an email, and we would be happy to help out.…
Easy Hacks to Make Your Exterior Wall Painting Last Longer
Are you getting ready to paint the exterior of your house? Make sure your paint job lasts longer by following these simple hacks. Exterior paints are designed to withstand the elements, but they can only do so if they are properly applied and maintained. Moreover, if you hire the best painter in Mornington, you don’t need to worry that the paint will chip easily. In this blog post, we will discuss how to protect your paint job from the sun, wind, rain, and snow. Ultimately, this post will help you make your wall painting last longer.
Clean Up Your Walls by Using a High-Pressure Washer
When it comes to making your wall painting last longer, one of the best things you can do is clean up your walls before painting them. This may seem counterintuitive, but it will help the paint to adhere better and last longer. Use a high-pressure washer to remove any dirt and debris from your walls. Just be sure not to use too much pressure, as this could damage the bricks or siding.
Apply a Primer Coat
Once you’ve cleaned up your walls, don’t hit your wall with your paint just yet. You need to apply a primer coat first. It will help the paint to better adhere to the surface of your walls and ultimately last longer. Choose a quality primer that is designed for exterior use. Apply the primer with a roller, following the guide. Then, let it dry thoroughly before moving on to painting your walls.
Always Use a High-Quality Paint
Now that you see the primer has been dried, you are almost ready to start painting your walls. But before you do, remember that it’d be better always to use high-quality paint. It is especially true for exterior wall paints. Good quality paint will be more durable and last longer than cheap paint. It’s worth spending the extra money on good quality paint, as it will save you money in the long run.
Apply at Least Two Coats of Paint
When painting your walls, be sure to apply at least two coats of paint. This will help to make your wall painting last longer. The first coat should be a thin layer, while the second coat can be a little thicker. The rule of thumb is to apply two or three coats of paint to cover the primer completely. Once you’re done, allow the paint to dry completely before moving on.
Protect the Painted Surface With a Sealant
 The last step in making your wall painting last longer is to protect the painted surface with a sealant. A sealant will help to keep the paint from fading, chipping, or peeling. Choose a quality sealant that is designed for exterior use. Apply the sealant according to the manufacturer’s instructions. Once you’re done, your walls will be protected, and your paint job will last longer. These are just a few easy hacks to make your wall painting last longer. By following these tips, you can be sure that your paint job will withstand the elements and look great for years to come. Be sure you take the time to do it right, and your walls will thank you.
The last step in making your wall painting last longer is to protect the painted surface with a sealant. A sealant will help to keep the paint from fading, chipping, or peeling. Choose a quality sealant that is designed for exterior use. Apply the sealant according to the manufacturer’s instructions. Once you’re done, your walls will be protected, and your paint job will last longer. These are just a few easy hacks to make your wall painting last longer. By following these tips, you can be sure that your paint job will withstand the elements and look great for years to come. Be sure you take the time to do it right, and your walls will thank you.
But if you think it’s too much of a burden, hiring a professional painter is always a good idea whether you are painting the interior or exterior of your house.…
Reasons to Hire Building Designers for Your Next Project
When it comes time to build or renovate a property, many people choose to do it themselves. While this can be a cost-effective option in some cases, there are several good reasons to hire building designers instead. This blog post will discuss the most important reasons to hire professional building design for your next project!
They Have Adequate Experience and Knowledge
 This is probably the most crucial reason to hire a designer. They have been trained in how to design functional and aesthetically pleasing buildings, and they know all the latest trends in the industry. Suppose you want your project to be designed correctly.
This is probably the most crucial reason to hire a designer. They have been trained in how to design functional and aesthetically pleasing buildings, and they know all the latest trends in the industry. Suppose you want your project to be designed correctly.
In that case, it is best to leave it in the hands of someone who knows what they are doing. for instance, a designer will learn how to properly proportion rooms and windows, and they will be able to choose durable materials stylish.
Designers Help Come up With Creative Ideas
If you are struggling to develop ideas for your project, a designer can help. They will be able to offer suggestions and advice based on their experience and knowledge. In addition, they may be able to show you some examples of their previous work so that you can get an idea of what they are capable of. Designers are also great at problem-solving. If you have a specific issue that you need to address, they will be able to come up with a creative solution that meets your needs.
They Help Save Time and Money
If you try to design a building yourself, there is a good chance that you will make some mistakes. This can cost you a lot of time and money in the long run. However, if you hire a designer, they will be able to catch any errors before they become costly problems.
They Make the Construction Process Easier
 It can be daunting if you have never been through the construction process before. However, if you hire a designer, they will be able to help you every step of the way. They can provide guidance and support so that you do not feel overwhelmed by the process.
It can be daunting if you have never been through the construction process before. However, if you hire a designer, they will be able to help you every step of the way. They can provide guidance and support so that you do not feel overwhelmed by the process.
In addition, they can use their experience to anticipate any problems that may arise to be dealt with quickly and efficiently. In addition, they will be able to design your building efficiently and effectively, saving you money in the long run.…
How to Clean the Bathroom Sink
Maintaining a “new” look in your bathroom is not difficult. Usually, regular cleaning is enough, but for those annoying stains that can build up over time, here are our top tips on how to clean your bathroom sink.
For Quick Cleaning
 For quick cleaning of the bathroom sink, you only need liquid detergent and a normal kitchen sponge. Close the cap and pour a small amount of detergent into the sink and hot water. Using the less abrasive side of the sponge, gently begin scrubbing the surface of the sink. When you are done, empty the water and wipe over the sink with a soft, dry cloth. This chore should ideally be done once a week, as well as in the bathtubs.
For quick cleaning of the bathroom sink, you only need liquid detergent and a normal kitchen sponge. Close the cap and pour a small amount of detergent into the sink and hot water. Using the less abrasive side of the sponge, gently begin scrubbing the surface of the sink. When you are done, empty the water and wipe over the sink with a soft, dry cloth. This chore should ideally be done once a week, as well as in the bathtubs.
Necessary Tools
- White vinegar
- Absorbent kitchen paper
- Bicarbonate
- Salt
- Lemons
Avoid using vinegar on colored porcelain as it can damage the surface and lead to discoloration. You should avoid it on marble because the acidic qualities of the vinegar will numb its brilliance. If you have a marble sink, we recommend using a microfiber cloth and warm water.
Cleaning the Bathrooms Sink
 White vinegar is one of the best products for cleaning your bathroom sink – not only is it easy to use, it even has antibacterial properties and is easily accessible.
White vinegar is one of the best products for cleaning your bathroom sink – not only is it easy to use, it even has antibacterial properties and is easily accessible.
1. Pour Vinegar Into the Sink
Start by closing the sink cap and pouring one and a half glasses of white vinegar into the sink.
2. Cover the Sink With Absorbent Kitchen Paper
Take some paper towels and dip in the vinegar. Place more pieces of paper around the edges of the sink and continue until you have completely covered it.
3. Leave for 20 Minutes
 Let it sit for 20 minutes, then remove the pieces of paper and wipe the sink with a clean, dry cloth.
Let it sit for 20 minutes, then remove the pieces of paper and wipe the sink with a clean, dry cloth.
4. Clean Any Accessories
- It’s also a good idea to soak any bathroom accessories like toothbrush holders and soap dishes in vinegar to give them a vigorous clean. The smell of vinegar is not pleasant, we know, but it will fade once it dries.
- If, for any reason, you want to avoid using vinegar, whether it’s because of the smell or the manufacturing material of your sink, you can also use baking soda, which is a great alternative.
- Simply wet the bathroom sink with hot water and sprinkle its surface with baking soda.
- Rub the entire affected area with a soft cloth to form a paste. Also, try to thoroughly clean the overflow area and the faucet base (or taps).
- After you are done, rinse the sink and wipe it with a clean cloth. The sink will look new.
Benefits of Hiring Pest Control Experts
It is essential to take care of pest infestation issues once you recognize them in your homestead. Since most of the pests can cause harmful side effects in your life, ensure that you look for the right alternative that can eliminate them from your house. Remember that these small annoying insects might end up damaging your property, and this means that you will have to pay for other unnecessary expenses to solve it. Make sure that you hire pest control Balmain experts to help you in getting rid of insects from your home. Here are the benefits of hiring pest control experts or specialists.
Eliminating Pests
One of the reasons why you need to hire pest control experts is that they will help in getting rid of unwanted pests. These specialists have the required knowledge on how to exterminate various types of pests. Even if insects, spiders and rodents invade your property, they have the skills and knowledge on how to solve them differently. Therefore, if you want to eliminate pests from your house, hire professional pest control experts.
Decreasing Risks
When you hire a professional pest control company, they will help you in eradicating pests that are inside your house. But if you hire inexperienced contractors for this work, they might use inappropriate elimination method that will end up causing other significant consequences to you and other residents in your compound. Ensure that you find professional experts who will help in reducing or decreasing such risks.
Identifying the Source
When you decide to work with an experienced pest control company, this means that you want to identify the source and get rid of these insects from your home. Also, they will be able to identify the primary source of this problem and look for a practical approach that will help in eliminating them. Note that you cannot solve this problem without locating the source. Therefore, once you identify the source of this issue, this means that you will eliminate pests.
Safe and Effective
It is no doubt that there are most dangers associated with pest extermination. When you are out there, and you want to deal with these pests, make sure that you are working with an experienced pest control company. They have the right tools and chemicals that will not affect you and your surroundings. In other words, their services are safe and effective.…
Why You Need Solar Installation in Your Home
Today solar energy is slowly becoming a popular choice of power for most people. Even governments are giving incentives and tax breaks to promote solar installation. There are chances that your property value can also go up due to the consumer awareness of environmental friendliness. Below are some of the reasons for solar installation.
Environmentally Friendly
 The rate at which human beings have been burning fossil fuels is degrading the planet and accelerating climate change. The major resources that people mine for power and heating homes are petroleum, natural gas, and coal. The greenhouse gases they emit build up in the atmosphere and overheat the planet steadily. Weather patterns are also changing with crippling effects on systems all over the world.
The rate at which human beings have been burning fossil fuels is degrading the planet and accelerating climate change. The major resources that people mine for power and heating homes are petroleum, natural gas, and coal. The greenhouse gases they emit build up in the atmosphere and overheat the planet steadily. Weather patterns are also changing with crippling effects on systems all over the world.
You can drastically slow down these effects by utilizing solar installation. Solar energy is renewable and clean. The panels make use of the photovoltaic system that converts sunlight into electricity. The electricity is then converted into direct current and alternating current for use in offices and homes. This process does not emit any greenhouse gases.
Cost-Efficiency and Self-Sufficiency
Utility bills are costly and keeping up with them can be hard. Relying on the sunlight reduces the price of buying energy. When you know you have some degree of self-sufficiency, you will have peace of mind. The future and economy are uncertain. There is, therefore, a lot of satisfaction in knowing that you can produce all or some of your own energy.
Sustainability

Fossil fuel and natural gas are doubly ominous since they are limited. Once you extract them from the ground, they are gone. Socioeconomic systems and individuals all over the world can get into dire straits when these energy sources are gone.
Solar energy is renewable. As long as there is the sun, photovoltaic panels will convert the rays into electricity. They also produce power in any situation meaning constant sunlight is not necessary. As long as you have the photovoltaic panels, they will reduce your carbon footprint.
Low Maintenance
The photovoltaic system usually requires little maintenance. It is also to get a company to install one for you. Better still, install solar panels. You may only need to call an installation company for repair purposes. This can be done at low prices.
These are some of the benefits you will get from the solar installation. You will impact the community and the nation as a whole by choosing to install a solar panel in your home.…
Quick Tips for Finding Tiles and a Roofing Company
When building a home, making sure you know the excellent types of tile roofing is among the major decisions that can make your house stand out. After hiring a contractor, many people do not contribute the ideas they have that can make their dream house a reality. So they leave the whole project to the contractor forgetting that they are the one who will be staying in that home. If you are planning on building a house or want to repair your aging roof, it is essential that you find quality tiles. And if this is the first time you are taking part in the construction or repair of your house, then you should know that tiles alone cannot make your home stand out. Therefore, you also have to find an excellent roofing company to fix them for you. Here are quick tips for finding tiles and the best roofing company.
 Online advertisements have been on the rise in the past few years, and the primary reason for this is that many people now use the internet. It is a fact that a significant number of the current generation depend on the internet for information. Excellent tile companies have known this trend, and therefore they now use the internet to reach potential clients.
Online advertisements have been on the rise in the past few years, and the primary reason for this is that many people now use the internet. It is a fact that a significant number of the current generation depend on the internet for information. Excellent tile companies have known this trend, and therefore they now use the internet to reach potential clients.
Reviews
With every company now able to create a cool website and market their services online, it is essential to know that not many of them can make that beautiful and quality roof. Therefore, you have to find a way to pick the best from the many that you will find on the internet. And the simplest way to select a roofing company is by reading reviews. Reading reviews and looking at the pictures of their previous project can be said to be the only way you can use the internet to prove that a company does quality work.
Referrals
 The other common yet excellent way to find quality tiles and a roofing company is through a referral. If you visit a friend or a relative who has a beautiful roof, it is okay to ask him about the tiles used and the roofing company that made the roof. People are always willing to refer their friends to companies that do excellent work.
The other common yet excellent way to find quality tiles and a roofing company is through a referral. If you visit a friend or a relative who has a beautiful roof, it is okay to ask him about the tiles used and the roofing company that made the roof. People are always willing to refer their friends to companies that do excellent work.
Visit a Company
After finding a roofing company using the internet or through a referral, it is essential that you also visit their offices. While at the office, you will get to negotiate the price and choose the tiles that you want.…
Selecting the Best Plantation Shutter Company
There are so many plantation shutter companies in the market, and each is promising the best of services. Customers especially first-timers get confused by the many companies and by the end of the day they make wrong choices. We advise customer’s to take enough time to research about plantation shutter companies in their locality before making a selection. You should only choose a company which will be able to guarantee their product. Below are some of the factors to look at in the selection of plantation shutter companies. Read on.
Experience
 It is important to ask the company for how long they have been in the market. The longer their operation duration, the better their services. The time of operation relates to reputation as well. The only reason why the company survived the market would be because of quality products and services.
It is important to ask the company for how long they have been in the market. The longer their operation duration, the better their services. The time of operation relates to reputation as well. The only reason why the company survived the market would be because of quality products and services.
On the same note, do not underestimate new companies in the industry. Since they are still finding customers and building their reputation, they might be offering better services compared to older companies. You might find that a young company has many customers because they did their best to attract and retain them.
Expertise
A company like Phoenix plantation shutters which specializes in shutters alone has an advantage over the others regarding quality and service. Since the company deals with shutters alone, they will be more focused on producing quality products and satisfying their customers. Think twice about a company which deals with shutters as one of its many products.
Support
 A reputable company will positively respond to you when you first approach them. From the first question about what they offer and if they can give you what you want, they will be open, and willing to answer all your questions to satisfaction. They will be open and ready to provide options or alternatives to the design you want. They are concerned about how you want to decorate your home, and they will offer you all the help within their capacity to see you smile.
A reputable company will positively respond to you when you first approach them. From the first question about what they offer and if they can give you what you want, they will be open, and willing to answer all your questions to satisfaction. They will be open and ready to provide options or alternatives to the design you want. They are concerned about how you want to decorate your home, and they will offer you all the help within their capacity to see you smile.
If you take time to research and make the right selection, you will be sure of quality products. Researching and doing your homework right is the first step towards finding the best plantation shutters for your house. Do not be in a hurry and do not choose companies based on cost only. Cheap is expensive, and the costly companies do not always deliver quality.…
Advantages of Hiring a Termite Exterminator
It goes without mentioning that dealing pests at home must be handled by professional pest control companies. However, homeowners tend to deal it themselves thinking it is costly to seek the assistance of the professionals. In addition to that, finding a pest control product in a local store is easy these days.

What they fail to realize is that a DIY approach when it comes to pest extermination is risky. Keep in mind that you will be dealing with harmful chemicals when getting rid of termites or any other pests. One must also invest in the right tools if they want to get rid of the pests for good. Homeowners must also remember that the task of dealing with termites is time-consuming. Read on to find out the advantages of hiring a pest control company.
Right Tools for the Job
If you rely on the products in your local store, then you will likely fail to come up with a long-term solution when it comes to exterminating the pests in your home. On the other hand, a professional termite exterminator is equipped with the right tools for the job. Hence, they have the ability to deal with the problem in the shortest time possible. What is more is that the tools they have will enable them to get rid of the pests for good.
 Professional Services
Professional Services
What separates pest extermination companies from you is that they offer professional services. This means that they invested their time as well as their money to become experts in matters concerning pest extermination. They underwent a series of training as well as seminars to learn more about this line of work. They also made an effort to register their business.
Long-Term Solution
Another benefit of hiring a professional pest control company is that they offer long-term solutions. This means that hiring them is economical in the long run. What is more is that the solutions they provide are guaranteed to be effective.
Effective & Safe
It is evident that there are dangers associated with pest extermination. If you do not know how to go about correctly dealing with pests, you will be at risk of health-related problems given that the chemicals used to get rid of the pests contain harmful substances. Keep in mind that covering your mouth or your nose is not enough to guarantee your safety when spraying the chemicals. In addition to that, you might not adequately address the problem because your expertise when it comes to pest extermination is limited.
Convenient
As what was mentioned above, the task of getting rid of pests is time-consuming. Therefore, you need to be committed to finishing the job if you decide to do it yourself. The problem is that you are likely to have other responsibilities if life such as reporting to work or managing your business. Of course, you do not want to spend your free time exterminating the pests in your home.
If you decide to hire a pest control company, all that you need is to call them then let them handle the pest extermination for you. Hence, it will be convenient for you since all you need to do is wait for them to finish the job.…
Benefits of Hiring Experienced Carpet Cleaners
Some people prefer cleaning their carpets to save money. This can be cheap, but it cannot give your carpet a professional look. Hiring a professional carpet cleaning company can provide you with a long-term solution. The challenges and benefits of DIY cleaning method mainly depend on one’s proficiency. You can get the services of these professional carpet cleaners by contacting reliable companies like 580 carpet cleaning professionals. The following are the benefits of hiring experienced carpet cleaners:
Give You Time to Focus on Other Important Activities
Hiring the services of these professionals will give you ample time and allow you to focus on other day-to-day activities. For instance, this will give you time for preparing snacks when you are expecting guests. Shifting your focus from detergent and brush is an effective way of improving productivity at home.
This Will Ensure Your Carpet is Safe

Inexperienced homeowners can ruin their carpet’s finishing by use of inappropriate detergents and cleaning tools. Outsourcing the services of these professionals will make sure that your carpets are in safe hands. Experts are known for using top-grade cleaning equipment making the cleaning process more safe, efficient and timely. In addition to this, these professionals will make sure that your carpet is properly disinfected to kill allergens and bacteria.
Save Money
Renting the powerful carpet cleaning tools is costly. Proper cleaning of your carpet will extend its life and save money in the long run since you will not have to replace it more frequently. Some of the reliable manufacturers have warranties that require the owner to clean the carpet on a regular basis. Your warranty will be declared void if you don’t hire an expert. This is an issue that can cost you a lot of money when replacing your carpet.
Health Conditions
 Professionals are known for doing a great job. You can enjoy many health benefits by hiring carpet cleaners. The experts hired will make sure that all dirt is removed from the carpet. Dirty carpets can harbor mites, dust, molds, fungus, and other unwanted health hazards. Most of these hazards can be eliminated by getting the services of professional cleaners.
Professionals are known for doing a great job. You can enjoy many health benefits by hiring carpet cleaners. The experts hired will make sure that all dirt is removed from the carpet. Dirty carpets can harbor mites, dust, molds, fungus, and other unwanted health hazards. Most of these hazards can be eliminated by getting the services of professional cleaners.
Improving Your Comfort
Living in a clean house is comfortable. Carpets that are well-cleaned will give your house a new feeling and smell. You will also feel good while walking on a clean floor. Taking care of the cleaning and vacuuming will help you in keeping that freshness and smell alive.…
Top Benefits of Using a Reclining Chair
Recliner chairs are known to have some form of luxury. Sitting on it will give you a relaxed feeling that is quite different from a wide range of seats. However, these chairs are not only meant to provide luxury but have tangible benefits. If you want to buy one, the following are some benefits you should consider:
Improves Blood Circulation
 If you work for extended hours, then you know that sitting for quite long will affect the blood flow. This will make you feel tired. Moreover, it is unhealthy and may result in different medical complications. Also, standing for long is also not good. This is because it can reduce the amount of blood flowing to the brain. This may cause fainting and other serious medical conditions.
If you work for extended hours, then you know that sitting for quite long will affect the blood flow. This will make you feel tired. Moreover, it is unhealthy and may result in different medical complications. Also, standing for long is also not good. This is because it can reduce the amount of blood flowing to the brain. This may cause fainting and other serious medical conditions.
Increase Productivity
There are several factors that influence a person’s productivity. Boredom is one of the elements because of lack of mobility. If you work in a busy environment, you will find it difficult to deal with boredom. This is necessary to help you refresh as you work. Thus, it can increase your productivity at no extra cost.
Improve Quality of Life
A lot of senior citizens have mobility issues that can affect their lives. The lift chairs are ideal for them as they can help them move down and up. This allows them to rest and carry out other basics like eating without issues. The good thing is that it offers you independence that can be a good source of happiness. This is because you do not have to lift it when doing simple tasks such as stretching your legs or lying down.
Ideal for Pregnant Women
 Most pregnant women suffer from lower back pain because of the baby’s weight. In fact, this makes it quite difficult for them to sit on the ordinary chairs. In this case, a recliner seat is the most ideal way of dealing with this issue. This is because pregnant women can just lie back and also distribute the weight throughout the body. This will allow you to rest your feet which makes it ideal for both the baby’s health and mother’s health.
Most pregnant women suffer from lower back pain because of the baby’s weight. In fact, this makes it quite difficult for them to sit on the ordinary chairs. In this case, a recliner seat is the most ideal way of dealing with this issue. This is because pregnant women can just lie back and also distribute the weight throughout the body. This will allow you to rest your feet which makes it ideal for both the baby’s health and mother’s health.
Aesthetic Purposes
You should note that recliner seats are available in a wide range of designs. When used in an office setting, it gives an impression of class and style.…
Why you should buy an electric power washer
You can cut through grime in no time when using pressure washers. From garage doors to floors, lawn furniture to lawn equipment, fences to decks, even cars to boats can be squeaky clean once you’ve rinsed them with the pressure washer. There is no doubt that this powerful tool can leave your surfaces spotless. If you are planning to do some spring cleaning and looking for using this wonderful device, the decision of what type you should use and whether you should rent it or buy it will be a dilemma.
Buying vs. renting a pressure washer
 Should you purchase it or should you rent it? It depends on your needs, how often will you use it, how much maintenance you can handle, and how much money are you willing to spend. The cost of renting one starts at around $60 a day while you can find one for around $150 for purchase. Upkeep and repairs are no worries of yours when you rent a pressure washer since you won’t be the one to pay for the repairs, but in retrospect, maintaining one is considered relatively easy. Depending on your usage frequency, how often you use the pressure washer is a determining factor in deciding whether owning one is a worthwhile investment. If you only need it for a day and don’t foresee needing to use it anytime in the future, then renting is the answer. If you need it several times a year to clean your dwelling and what comes with it, buying and owning one is the way to go for cost-effectiveness and convenience.
Should you purchase it or should you rent it? It depends on your needs, how often will you use it, how much maintenance you can handle, and how much money are you willing to spend. The cost of renting one starts at around $60 a day while you can find one for around $150 for purchase. Upkeep and repairs are no worries of yours when you rent a pressure washer since you won’t be the one to pay for the repairs, but in retrospect, maintaining one is considered relatively easy. Depending on your usage frequency, how often you use the pressure washer is a determining factor in deciding whether owning one is a worthwhile investment. If you only need it for a day and don’t foresee needing to use it anytime in the future, then renting is the answer. If you need it several times a year to clean your dwelling and what comes with it, buying and owning one is the way to go for cost-effectiveness and convenience.
Electric powered vs. gas powered
There are two main types of pressure washers; an electric powered one and a gas powered one. Finding the right type depends on what you will you use it for and how much time do you have. For lighter-duty jobs, electric ones work best if you want to clean your decks and patios or furniture. For heavy-duty jobs, gas-powered ones are your go-to for quickly cleaning large areas and tough stains. The gas type is more powerful and faster to clean with, but it needs a little extra effort for fuel-mixing, pull-starting, and tune-ups. While the electric one has less pressure which means slower cleaning, it is relatively light and quiet with little upkeep. A less costly electric power washer will work as well as a gas one, it will only take longer to finish up. Read up on reviews of the best electric power washers and gas ones to help you make the decision.
Conclusion
 The choice of it all comes back to you. It depends on all your considerations. If you want one-time cleaning with fast results, then renting a gas power washer is the way to go. If you plan on investing one for frequent use and convenience while it’s easy on the wallet, then you should buy an electric power washer.…
The choice of it all comes back to you. It depends on all your considerations. If you want one-time cleaning with fast results, then renting a gas power washer is the way to go. If you plan on investing one for frequent use and convenience while it’s easy on the wallet, then you should buy an electric power washer.…
Questions to ask professional carpet cleaning company
It is always a risk when you hire a professional company to carry out work for you, especially if you have never used them before. You may have been the unfortunate customer who hired the local cowboys that could not carry out the job efficiently, or perhaps you were greeted by rude staff. Whatever the problem was, it is not a nice experience to have to endure. If you are looking for the professional carpet cleaners that can do the job properly while maintaining an excellent standard of customer service, there are a few things you should ask first.
Questions
1. How long have you been in the carpet cleaning industry?
 This should give you a good idea as to how reliable the company is, if they have been in business for let’s say 20 years, they must be doing something right. However, just because a company is newly established does not make them “dodgy,” it’s just something to consider.
This should give you a good idea as to how reliable the company is, if they have been in business for let’s say 20 years, they must be doing something right. However, just because a company is newly established does not make them “dodgy,” it’s just something to consider.
2. How do you charge?
Many carpet cleaning companies will provide you with a quotation for your job before they start but once inside your home will start adding on additional costs. This is called ‘bait and switch’ and is a well-known tactic within the industry. It is important that you check with the cleaning company that their quote is the final price you will pay. As well as avoiding bullish sales tactics, this also allows you to compare quotes easier.
3. What cleaning method does your company use?
There are several different professional carpet cleaning methods, namely dry cleaning and steam cleaning (or hot water extraction). It is very important that you look for a company specializing in steam cleaning as this is the only method to be recommended by both industry bodies and carpet manufacturers. Alternative methods simply move the dirt around the carpet providing the appearance of being clean, but not actually removing any contaminants.
4. Do you offer any other services?
It is quite common for professional carpet cleaners to offer additional services such as sofa cleaning, curtain cleaning, stain removal, upholstery cleaning and so on. You might want to ask your carpet cleaner if they provide any of these extras as you could save money by bulk buying.
5. What happens if I’m not happy?
 Your carpet cleaner should have a 100% guarantee in place, meaning that if you are not satisfied with your cleaning result, the technician should return to clean the area again free of charge. If they did not provide you with a solution, I would avoid this company at all costs.…
Your carpet cleaner should have a 100% guarantee in place, meaning that if you are not satisfied with your cleaning result, the technician should return to clean the area again free of charge. If they did not provide you with a solution, I would avoid this company at all costs.…
Features of executive condominium
A condominium refers to a building containing a number of individually owned housing units or apartments. Since the use of condominiums originated in Utah in 1960, their use has significantly increased over the past years. What then is an executive condominium? Well, then an Executive condominium is a strata-titled apartment with facilities comparable to private condominiums. With the steady increase in the use of the Executive condominium over the years, people fear and know the possibility of a further price decline is very low. It is, however, important to note that the executive condos are very popular in Singapore and Philippines. The Rivercove Residences ec has some of the best housing units. Features of an executive condominium include:
Comfort and luxurious

Executive condos are parked with comfort, luxury and security which make them suitable to those that have busy lives. Presence of fitness rooms, swimming pools, country clubs, sky lounges and golf clubs make them more luxurious. The great social amenities offered by the executive condos makes them have an upper hand when compared to other residential places like the houses. Also, the lazy individuals are saved the effort tending lawns and gardens and repairing fixtures in a house which of course come with a price.
Accessibility and proximity
The executive is mostly accessible to cities which make it simple to access social amenities and services like healthcare, banking services, malls, entertainment areas, commercial establishments and access to education facilities. All that promotes a trouble-free and hassle-free living. This is a clear and good reason why the acquisition of executive condos is the latest trend in home owning.
Quick reselling features
The executive condo’s amenities, building features, lesser cost and proximity to adequate social amenities give it faster-selling chances than houses in case the owner decides to sell it.Most of the executive condos are just minutes away to prime city hubs which make them have the edge over the houses. This explains the importance of executive condominiums locations.
Limited choices by location
As earlier said, executive condominiums are located in areas with close proximity to city centres.Since executive condominiums are the best, the choice of selecting the best over an area is however very limited.
Presence of additional benefits

Owners who purchase the Executive condos for the first time are normally given housing benefits in form of grants through the application. Second timers buying new Executive condos are normally exempted from paying any resale levy.The benefits may differ depending on the Executive condominium. Another important feature of Executive condos is that their values increase after a period of time.…
Things To Look At When Looking For A Rental House
Finding a rental home is a simple task. This is probably caused by the fact that many people have seriously invested in rental houses. However, you need to distinguish between finding a rental home and a perfect rental home. There is a great difference between the two. Most people desire to have a perfect rental home, and yet they do not know on how to exactly achieve that. If you are looking to live in Toronto rentals, then this article can be of great help to you. Here are some of the things that you need to look at when looking for rental homes.
The management
 The first thing that you need to is to learn about the management of the rentals in question. If they are doing great work on their side, then it means that you will be able to lead a smooth life as long as you live in their rentals. Understanding the management of the rental will also help you to know who to contact whenever you have any problem. You also need to know how management reacts to the problems of their clients. If they take a lot of time to solve problems, then that is an indication that you need to keep searching.
The first thing that you need to is to learn about the management of the rentals in question. If they are doing great work on their side, then it means that you will be able to lead a smooth life as long as you live in their rentals. Understanding the management of the rental will also help you to know who to contact whenever you have any problem. You also need to know how management reacts to the problems of their clients. If they take a lot of time to solve problems, then that is an indication that you need to keep searching.
The neighbours
You also need to find some information about your potential neighbors. You have it was said that no man is an island. This is a wise saying that is meant to underscore the fact that your neighbors can play a significant role in ensuring that you lead a comfortable life. So take a moment to say hi to the neighbors and see if they are friendly or not. Be sure to understand them a bit. Another that you need to know is that you cannot lead a comfortable life if you are afraid of the person in the next door.
Amenities nearby
 Amenities are basic requirements if you are to lead a comfortable life. So while looking for a home, it is good to ensure that you find the rentals that are close to basic amenities like hospitals and schools. Other things that you need to also look at is things like laundry. However, if you find out the rentals provides such amenities to people living around, then you can learn to share them with other tenants. The underlying point here is that you need to understand the settings and the community around the rentals.…
Amenities are basic requirements if you are to lead a comfortable life. So while looking for a home, it is good to ensure that you find the rentals that are close to basic amenities like hospitals and schools. Other things that you need to also look at is things like laundry. However, if you find out the rentals provides such amenities to people living around, then you can learn to share them with other tenants. The underlying point here is that you need to understand the settings and the community around the rentals.…
How To Select A Credible Plumber
It is possible to have emergency plumbing issues in a home now and again. Thus, you need to find the best plumbing service to help resolve them and ensure your home is safe. Choosing the right plumber can be stressful particularly if you are not sure where to start from. Not every person qualifies to be a plumber even they claim to be. In fact, there are experts that do not know how they can talk to customers to create a good relationship. Nowadays, there are several factors, which can affect your choice of a good plumber.
Process of choosing a plumber
Choosing a plumber is a process that requires utmost patience and care. The following are some of the steps to undertake:
Recommendations
You can begi n by asking neighbors, colleagues, and friends. This is quite important as it offers you the assurance of their reputation. However, the majority of homeowners do not consider this as the right approach. It is advisable to use plumbers that are recommended and have excellent ratings from family, neighbors, or friends.
n by asking neighbors, colleagues, and friends. This is quite important as it offers you the assurance of their reputation. However, the majority of homeowners do not consider this as the right approach. It is advisable to use plumbers that are recommended and have excellent ratings from family, neighbors, or friends.
Check online directories
If this fails to work, you can check through different online directories to find the right plumbers to carry out the work. One of the downsides is that when you use a directory, you are not able to determine whether the plumber you choose is an expert or not. In any case, being listed in an online directory does not mean that the plumber is reputable. Good plumbers are not only good at work but also where customer relation and services are concerned. Before you hire a plumber, it is necessary to have a good idea of what the problem is and the cost estimate. There is nothing wrong with calling several plumbers to find out their capability for the task at hand.
Price quotes
Ensure you as k for the price estimates that fit your budget needs. Never be carried away with plumbers that provide cheap quotes as you may end up regretting it. You may also choose to contact builders and contractors in your area since they work with some credible plumbers. In this way, you can get professionals that can offer you a perfect plumbing fix.
k for the price estimates that fit your budget needs. Never be carried away with plumbers that provide cheap quotes as you may end up regretting it. You may also choose to contact builders and contractors in your area since they work with some credible plumbers. In this way, you can get professionals that can offer you a perfect plumbing fix.
If you cannot go through such selection process before an emergency, you can call a local plumber that is listed in the directory. Give them a tour of your home and ask for a quote.…
What It Takes to Find The Best Locksmith
Some people have never enlisted the services of a locksmith. Even if you have never worked with a locksmith, chances are that you will need to work with one someday. For instance, losing your car keys or locking yourself out of your home might force you to work with a professional locksmith. As far a locksmithing services are concerned, you have every reason to work with a professional and experienced locksmith. Here are some tips that will lead you to the right locksmith.
Get recommendations
There are many locksmiths today. As such, the best way to narrow your search to reputable ones is to get recommendations. Get a couple of suggestions from friends, colleagues, or family members that have worked with a locksmith. With a few names, it becomes easy to get the best and avoid those not so good ones. As much as a possible, see to it that you do not work with an inexperienced locksmith.
Check qualifications
The qualifications of a locksmith can tell you what they can do and what they cannot. Thus, when looking for a locksmith, it is imperative to go through their qualifications with the sole objective of understanding what they can offer. Ideally, you should be looking for someone who can help you with installation, replacement, repair, and general upkeep of security locks. Hiring a qualified team is the only sure way of ensuring your home is secure and safe.
Look for license and insurance
It is also important to work with a licensed team when working on your door locks. This assures you that you are working with a qualified team that uses ethical approaches. This way, you do not have to worry about things like security breaches. Besides this, you also need to work with a locksmith with an insurance policy. This insurance policy should cover both general liability and workman’s compensation.
Find out availability and reliability
 As much as you are looking at the professionalism and reputation of a locksmith, the reliability of a locksmith is one of the most important things you can get from a locksmith. Reliability means that you will always have someone you can rely on in case of an emergency. Thus, before hiring a locksmith, to see to it that they are reliable.
As much as you are looking at the professionalism and reputation of a locksmith, the reliability of a locksmith is one of the most important things you can get from a locksmith. Reliability means that you will always have someone you can rely on in case of an emergency. Thus, before hiring a locksmith, to see to it that they are reliable.
The tips shared above, if well-implemented will undoubtedly improve your chances of getting the right locksmith.…
What to consider when choosing an electrician
Being ready for any electrical emergency is to have an agreement with a reputable electrical contractor. You should note that electrical problems are the leading causes of fires in homes and those concerns ought to be addressed by a professional and licensed contractor. The stress levels elevate in case of an emergency.
It is unfortunate that some homeowners do not have a clue on what to do. This is the reason to contact a reliable electric repair contractor even before the emergency occurs. In so doing, you can eliminate the stress of dealing with electrical emergencies.
Hiring the right technician
There are various things you can evaluate when hiring an electrician. The following are some of them:
Licenses and certification
 Electricians deal with work which affects the safety of a home. It is necessary to hire electricians that have appropriate certificates and licenses. Remember that every state has its policies as far as issuing licenses is concerned. Other than the professional license, an electrician must have a business license and other related permits.
Electricians deal with work which affects the safety of a home. It is necessary to hire electricians that have appropriate certificates and licenses. Remember that every state has its policies as far as issuing licenses is concerned. Other than the professional license, an electrician must have a business license and other related permits.
Experience
Other than permits and licenses, it is necessary that electrical contractors have a lot of experience in doing contractor jobs. This ensures that there is adequate client feedback available.
Continuing education
It is vital that an electrical contractor continues to improve his or her skills through continuing education. Thus, the contractor should be attending training and seminars on a regular basis. Moreover, attending such workshops ensures that the knowledge of electrical contractor remains up-to-date. Also, it makes an electrician know the top practices in this given industry.
Insurance
It is necessary that electrical contractors have liability insurance. This protects clients in case anything goes wrong during the repair work. They will be assured finance that can be used for replacements and repairs related to damage that occurred.
Quality of work
 This is an important factor which should be taken into account when hiring reputable electrical contractors. Some of the indicators to take into account include customer reviews, feedback, and testimonies from neighbors and friends who may have recommended the contractor.
This is an important factor which should be taken into account when hiring reputable electrical contractors. Some of the indicators to take into account include customer reviews, feedback, and testimonies from neighbors and friends who may have recommended the contractor.
Cost
The cost of repairs should not be the main consideration when hiring electricians, though it is an important factor. Your contractor should be upfront about costs. He or she should provide you with a written estimate that is free of hidden costs and accurate. Also, the electrician should give you a warranty of his or her services.…
Signs That You Need Window Replacement
Windows are one of the most important components of any home. So when you see that there are wearing out or they longer look attractive like they used to sometimes back, the best thing to do is to have them replaced. One important thing that you should always remember is that not all window installation companies that are capable of giving you that perfect services that you need. This, therefore, tells you that you should be keen when looking for window installation company. Always give extensive research the top priority. This article provides you with signs that you need to have double glazing Glasgow for your home.
Not enough protection
 When you realize that the current windows are not protecting you from the common weather elements, then that is a sign that you need to have them replaced. When there is moisture that is trapped inside the glass, then it means it means the windows are broken. With such defective windows, you will never have peace of mind while in your home. The freezing winter wind, the house will never be comfortable as you would have wanted it to be.
When you realize that the current windows are not protecting you from the common weather elements, then that is a sign that you need to have them replaced. When there is moisture that is trapped inside the glass, then it means it means the windows are broken. With such defective windows, you will never have peace of mind while in your home. The freezing winter wind, the house will never be comfortable as you would have wanted it to be.
Grease needed
If it becomes difficult to open and close your windows, then that is a sign that there is something wrong with your windows and therefore need to be replaced. With time, the friction caused by opening and closing leads to the breakdown of mechanical components of your windows. If you do not replace them first, it means that you will have to cope up with the external air that will find its way into the room. You not to understand that if your windows cannot rock properly, you are facing a safety hazard that can leave you in great loss.
Bad look
 Another sign that shows you that you need to have window replacement is the look. One thing that you need to understand is that windows play a significant role in enhancing the look of your home. So if you realize that the look of your home is never appealing like it is used to be before, you do not have to worry about that. Just get a good window installation company have your windows replaced with decent windows like double glazing Glasgow and you will like the new look. You, however, need to make sure you get the right company since not any company can do a perfect job that you desire.…
Another sign that shows you that you need to have window replacement is the look. One thing that you need to understand is that windows play a significant role in enhancing the look of your home. So if you realize that the look of your home is never appealing like it is used to be before, you do not have to worry about that. Just get a good window installation company have your windows replaced with decent windows like double glazing Glasgow and you will like the new look. You, however, need to make sure you get the right company since not any company can do a perfect job that you desire.…
Effortless Ways To Control Pests
Pests are destructive to property and a risk to human health. They affect normalcy and reduce the quality of your everyday life. They thrive in almost any given environment and reproduce rapidly to increase in numbers within a short span of time. There are several effective ways of pest control, but the easiest, affordable, safe and comfortable method is through preventative measures.
Safeguard your homes, offices, commercial premises, gardens, parks, sidewalks and hospitals against notorious and harmful pests. Examples of common pests are cockroaches, bed bugs, fruit flies, house flies, fleas, jiggers, ants, ticks, lice, mice, rats, moths, and beetles. The following Bellator Pest Control Steps will help you effectively achieve pest control
Ways to control pests
Seal entry points
 Pests are minute in size and can easily get into buildings through cracks, crevices, holes and any other unattended openings available. Inspect your home for such openings and ensure they are properly sealed. Keep the area around buildings well mowed, attend to bushes and remove any objects likely to harbor pests. Keep gardens free of weeds and well watered.
Pests are minute in size and can easily get into buildings through cracks, crevices, holes and any other unattended openings available. Inspect your home for such openings and ensure they are properly sealed. Keep the area around buildings well mowed, attend to bushes and remove any objects likely to harbor pests. Keep gardens free of weeds and well watered.
Ensure the trash cans have well fitting lids and they are emptied regularly. Tale tell signs To determine whether your home or garden is infested or not, look for the following signs insect droppings, wings, crawling insects on the floors or walls, for wood ants the infested wood will produce some dust and will sound hollow on tapping. For parasitic pests such as lice and fleas, there will be itching in humans and pets. For garden pests, there will hole on leaves of the plants.
Hygiene
The majority of the household pests are controlled through good hygiene. Ensure the kitchen floors, the counters and utensils are cleaned up after every use. Dispose of the food remains in a sealed bin. By proper waste disposal, the pests are controlled through starvation. To get rid of fruits flies, do not keep excessively ripe and cut fruits in the open. Fleas and bedbugs are hard to control when the pests infest in the rugs and blankets. Ensure your rugs are cleaned frequently. The house must be vacuumed, dusted and mopped often.
Use of pesticides
 Controlled use of pesticides is important to ensure there is no introduction of harmful chemicals to the environment. The recommended pesticide for household pests is Boric acid. Apply this on places where the pests are most likely to be found. It is effective on crawling insects such as ants and cockroaches. Use environmentally tested fumigants on flying insects such as moths. For large-scale infestation is it advisable to involve a team of experts.
Controlled use of pesticides is important to ensure there is no introduction of harmful chemicals to the environment. The recommended pesticide for household pests is Boric acid. Apply this on places where the pests are most likely to be found. It is effective on crawling insects such as ants and cockroaches. Use environmentally tested fumigants on flying insects such as moths. For large-scale infestation is it advisable to involve a team of experts.
Conclusion
Make your home safe, comfortable and pleasant to come back to every evening by employing the expert Pest Control guidelines given above. Keep your families in perfect health by controlling pests such as rats which carry disease-causing microorganisms.…
Why You Should Use Portable Fish Finders
People fish for various reasons; there are those who fish for a living and there also those who fish for a hobby. Regardless of the reason for fishing, the whole experience of the fishery need to be as enjoyable as possible. One thing that you should always put at the back of your mind is that the whatever equipment you use in your endeavors will determine whether you enjoy the whole experience or not.
Perhaps one of the most advancements in the fishing industry is the development of portable Fish finders. This equipment is a sure way of giving back your money as far as the matters related to fishing are concerned. In this article, we shall explore some of the benefits that one one is likely to get buying a portable fish finder. Here are some of those benefits.
Location
Like the name suggests, this equipment can be taken to any place with you be used for in various locations. Whether you are enjoying a weekend fishing or you doing your regular task, fishing from a boat or any kind of water craft will never present a challenge as far as the portable fish finder is concerned.
Flexibility
Another advantage that you are likely to get by investing in this machine is flexibility. A fish finder normally has a castable transducer. This is imperative when it comes to moments that you need to fish in the areas that are tricky and difficult to maneuver your watercraft. Another important role played by this device is that once cast in the location of your wish, it gives you a good structure and idea of whether there are fish to target or not.
Stealth
The castable transducer is also capable of giving you the competitive edge of stealth that you need in your endeavor. It is in most instances advised that you place the transducer in the place that you dim suitable without having to move your noisy boat. This will help in preventing the disturbance of-of your target.
Specialty fishing
 What one of the most outstanding befit of a fish finder is that it has a lot of advantages that makes the top demanded equipment in the market. As much as specialty fishing can be provided with other technologies like sonar technology of a portable fish find, it is important to note that all the units of this machines offer perfect services. Some units are made in such a way that they can withstand extreme cold and other harsh conditions. Your transducer can be used anywhere on earth.…
What one of the most outstanding befit of a fish finder is that it has a lot of advantages that makes the top demanded equipment in the market. As much as specialty fishing can be provided with other technologies like sonar technology of a portable fish find, it is important to note that all the units of this machines offer perfect services. Some units are made in such a way that they can withstand extreme cold and other harsh conditions. Your transducer can be used anywhere on earth.…
Reasons you should remove molds in your home
A few problems could exist without your knowledge for a pretty long period of time. But, the day you learn about them, and they become known to you, it could be disastrous. One of such problems is molds. Sadly, everyone does not treat mold removal on a priority basis. This could be life endangering and unsafe.
To give you a better understanding, here are the reasons you should remove molds in your home
1. All molds can cause health issues.
 Some are more serious than others, depending on the type of mold and the sensitivity of the person. There are many mold species; some are harmful while others are not. But either way, you should eliminate them. It is crucial that you protect yourself and your family from being exposed. Removing molds and knowing when to call a professional is critical to keep you and your family protected. Look for the best company and
Some are more serious than others, depending on the type of mold and the sensitivity of the person. There are many mold species; some are harmful while others are not. But either way, you should eliminate them. It is crucial that you protect yourself and your family from being exposed. Removing molds and knowing when to call a professional is critical to keep you and your family protected. Look for the best company and
2. Help to control the moisture in your home.
Moisture could build up in the different areas of your home and this could be due to various reasons. You should eliminate the moisture first and fix the plumbings. Make sure that your home has enough ventilation in the kitchen and the bathroom because these areas can easily get humid. You can also use silica gel and other products that absorb moisture in closets and other enclosed spaces.
3. To avoid death.
There are instances when death has taken place by merely touching such molds, forget about the removal. In such situation, you need expert services to help you overcome this problem. Mold growth happens because of water leakage and to clean up the mess, you need expert services. Mold removal has to be initiated in a professional way. Professional services are best suited for this purpose. A professional can understand better how to deal with the mold, and they have latest techniques to undertake the removal plan that yields for the clients.
There are instances when death has taken place by merely touching such molds, forget about the removal. In such situation, you need expert services to help you overcome this problem. Mold growth happens because of water leakage and to clean up the mess, you need expert services. Mold removal has to be initiated in a professional way. Professional services are best suited for this purpose. A professional can understand better how to deal with the mold, and they have latest techniques to undertake the removal plan that yields for the clients.
If you have come across some pungent, smell coming from your house. Then, first and foremost, you must check out all water leakage, if you find that there are some then clean up that mess and the next smart step that you can take is call for professionals who are experts in delivering quality services for mold removal.…
Tips on moving your office
Office moving can be very challenging because you have to prepare all members of staff for the move. The best way to organize an office move is to make sure that you plan it as early as possible. Just like house moving; you should never underestimate office moving because you need to organize everything. When moving your office, you will be required to move your documents, furniture and also machines like computers and printers. Hiring a commercial moving company is the best way to move effectively from one office to another.
How to move your office
Prepare your staff
The first step is to prepare your staff for the big move. Your members of staff need to know that you will be moving soon and this is a good way to avoid the last minute rush. Once your members of staff know that you will be moving, they will start organizing their items in advance. By the time you decide to move, it will be easy for your staff to put all their items together in the shortest time possible.

Look for a mover
It is impossible to move your office without getting the services of a moving company. Make sure that you hire a moving company to make your office move successfully. There are many moving companies available and it important to make sure that your hire the right one. When hiring a moving company, make sure that you look for a company that has experience in office moving. Experience in office moving will make the entire process stress-free.
Come up with a packing list
A packing list is a good place to start when you finally set the date that you want to move. With a packing list, you can be sure that you won’t forget anything during the process of packing. You can come up with a packing list for each member of staff as well as the general packing list to help you with organizing. The packing process is the most stressful part because you have to make sure that you don’t forget or lose anything.

Make plans with the mover
Once you come up with the specific date for moving, it is now time to make plans with the mover. You need to inform the mover early in advance because most of the movers are booked for days. The earlier you inform your mover, the easier it becomes to move at the right time.…
What will a residential property company do for you?
A residential property company is an important entity to the real estate property owners. Property owners might not have the expertise to manage their property, and so they give the job to a residential property company. As a property owner, once you contract the management of your property to a company, all you have to do is wait for the pay cheque at the end of the month.
Services offered by a residential property company
Vet and admit tenants
If you are a property owner, you don’t just allow anyone to rent your property. You need to do some vetting and background checks of the tenants. Vetting will make sure that you only admit the right people to live in your property. A residential property company will help you with the process of vetting and admitting tenants. Property companies have all it takes to do a proper background check before allowing any tenant to your house.

Enforcing tenancy agreements
The tenants have to sign a tenancy agreement before they can live in your house. The agreement stipulates the rules that govern tenancy in your property. A property company will make sure that the tenants adhere to the tenancy agreement to avoid any problems while living in your property.
Managing the property
A residential property company will help you in managing the property. Management of the property involves making sure that the property is in good condition for the tenants to live comfortable. The property company will organize repairs, repainting and also cleaning of the property.
Rent collection
Rent collection is also a big part of the work of a property management company. The company will make sure that all the tenants pay the rent on time and the money reaches you on time. As a property owner, you don’t have to be actively involved in the process of collecting rent. Rent collection can be tedious especially if you live far away and you don’t have the time.

Managing tenants
You will be surprised to know that managing tenant is also important in residential properties. The tenants have to adhere to the tenancy agreement, and they have to live in harmony. A property management company will make sure that all the tenants live in harmony and every tenant lives comfortably. The property company will solve disputes between the tenants and attend to the complaints and concerns.…
HOW TO HIRE AN INTERIOR DESIGNER
Interior design is the art of improving interiors of a house or a building to make it more suited and more attractive to the owner. The science behind interior design is solely based on desires and ideas of the occupant. An interior designer is hired to create your ideal home space. It is, in this regard, prudent to engage the services of an interior designer. An interior designer is a professional that is hired to manage and facilitate interior design assignments.
In principal, an interior designer is charged with the responsibility of space planning, construction management, conceptual development and of course the execution of the desired interior design concept. Interior designers should be highly skilled and trained to construct interior environments that are well-designed, safe, and fulfill the requirements of the space owner. There are basic tips you can use when hiring an interior designer. They are listed as follows;
Referrals
 When hiring an interior designer, it is always easy to get information from family, friends, and professionals. Consult your neighbors and friends whose homes you’ve seen that you liked. Real estate agents are also resourceful. You should hire a reputable Interior design company for your house. Similarly, if you see something in a magazine or an online article, those are great places to start. Once you have come up with a list of desired interior designers, research and obtain enough relevant information to help you settle on one.
When hiring an interior designer, it is always easy to get information from family, friends, and professionals. Consult your neighbors and friends whose homes you’ve seen that you liked. Real estate agents are also resourceful. You should hire a reputable Interior design company for your house. Similarly, if you see something in a magazine or an online article, those are great places to start. Once you have come up with a list of desired interior designers, research and obtain enough relevant information to help you settle on one.
Cost
Leading consultants have stressed the importance of being upfront about how much money you’re willing to spend on your design project. Various interior designers have different fee structures. Hiring, therefore, depends on a budget of the hirer. If you’re working on a tight budget, don’t assume that hiring a designer is not possible. However, a bigger budget gives the hirer freedom of hiring the best interior designers.
Objective
As cited earlier interior designers are professionals and different designers have different skills. Some specialize in renovations while others fancy working with new construction projects. Deciding your desired project and planning ahead will also help you find the right designer for your project and home. It is prudent that the designer’s specialty is in line with your needs. This information could be obtained through websites of specific designers. Through the photographs that are on such websites, you can get a vivid idea about style and whether you like what the designer specializes in.
Availability
Your home is a priority in your life and therefore the desired interior designer should be able to treat it as such. It is of vital importance that you engage and consult with different designers regarding their schedule and availability to ensure that they will pull all their resources and time in your project.…
Features Of A Good Home Security System
 Getting a home security system is a wise choice to keeping your home, valuables and loved once safe. Likewise, buying a home security system contract from a reliable company is a sound purchase and a quality investment. This system will go a long way in improving your security and helping your physical and mental well-being.
Getting a home security system is a wise choice to keeping your home, valuables and loved once safe. Likewise, buying a home security system contract from a reliable company is a sound purchase and a quality investment. This system will go a long way in improving your security and helping your physical and mental well-being.
Good Home Security System Features
Live Monitoring
Make no mistake about it: no alarm system is worth a dime if it does not have live monitoring. A live monitoring service puts the responsibility of protecting your home in the hands of qualified professionals and local law enforcement. For more visit Dallas alarms. Likewise with such a system if you are out of town, then an emergency signal can still alert a command center representative, who can then call for an investigation into the alarm.
Manual Panic Button
While automatic features are always nice, and sometimes very necessary, one of the most important features that cannot be overlooked is the manual panic button. This allows you to sound an alarm immediately. You can use this button in the event of a medical emergency, or if an intruder is spotted on the outside of the home, or even if an invited guest suddenly becomes hostile. The little button gives you full power over your house.
Interconnected
While you have the option to buy home security devices separately, the best way to protect your family and your property is to have a whole system working as one.
Motion Detection
The system needs to be able to differentiate various pressure motions. There is nothing more troublesome or embarrassing than to summon a dozen police cars to your house and then only to find that a harmless pet cat or dog is the “perpetrator.” The advantage of the new high-tech security system is that it comes with pet detecting sensors that can differentiate the movements of a small animal from those of a human intruder.
Additional Sensors
Today’s advanced home security systems can protect residents not only from criminals and burglaries but even from some common household accidents. There are automatic and manual sensors that can signal fire, flooding, smoke and carbon monoxide.
Battery Back Up
 This is an often overlooked feature that cannot be ignored. An electricity-based home security system is all well and good; but what happens when the lights go out, and the criminals take note? A smart criminal would take advantage of a bad storm or neighborhood power outage? By installing a battery backup system, you will always be covered regardless of the circumstance.
This is an often overlooked feature that cannot be ignored. An electricity-based home security system is all well and good; but what happens when the lights go out, and the criminals take note? A smart criminal would take advantage of a bad storm or neighborhood power outage? By installing a battery backup system, you will always be covered regardless of the circumstance.
Tips for buying a water softener
If you are reading this article, you may be living in an area that has large limestone and chalk deposits that are causing the water to have excess minerals. Hard water has been a problem for many people as it leaves limescale on kettles, shower heads, and other plumbing fittings. Read more of this article, and you will learn what causes hard water and how you can rid your home of the issue.
What is hard water?
It is water that has excess minerals. It happens when underground water springs travel through chalk and limestone deposits. The minerals get dissolved into the water, and it will find its way to your home. Once you have noticed the signs and perhaps seen huge buildups on your shower heads and pipes, it is time you get a water softener installed in your home.
What is a water softener?
This is a device that helps reduce the mineral content in ground water. It contains a special resin that is capable of trapping the calcium and magnesium ions and only allowing soft water through. The unit consists of two tanks of which one houses the resin while the other has a cleaning solution which uses table salt or a special salt. If you want to purchase one of these units, there are a few things that you need to take into consideration,
Capacity
Water softeners come in many sizes. It is, therefore, important that you buy one that can handle the water consumption in your home. On average a person uses 20 gallons of water a day, therefore, if you have five people in your home you will need a with a 100-gallon capacity.
Space requirement
The unit will need adequate space for installation. You will have to connect it to the primary inlet of your home. Any water that goes through the water softener will be soft water, and you will soon not have to worry about the inconvenience again.
 Cost
Cost
The cost of the unit will depend on the capacity and the method used for removing the excess minerals. There are some types that use an electrical method as well, but the salt based ones seem to be more favored among homeowners.
Conclusion
Hard water can be a real annoyance when it starts clogging taps, showers, and pipes It can also ruin appliances like kettles, washing machines, and dishwashers. Get a water softener installed and all your troubles will be gone.…
How to Get Rid of Mice In Your Home
You would possibly looking for efficient ways to get rid of mice for you might be confronting lots of problems of having mice at your home. Looking one way after other and being dissatisfied in very common today. The reason is, when you use a trap to get rid of mice, you can catch a few mouse. Next, they got down to develop consciousness about the approach you make use of and so they learn how to avoid from them. Now you have to search for another way and on it goes. Click here for the mice control in London.
How to get rid of the mouse
1. Use a cat
 In this never ending struggle to get rid of mice, the better option would be to convey a cat and grow it in your house. When the mouse hears the ‘mew’ noise of cat, it will evade away to some far off places. The cats are the actual terrible scenarios for the mice. Having a cat as a pet is safest and cheapest method to eliminate mice. The cat will control the trouble for you and will give you a safer home without rodents.
In this never ending struggle to get rid of mice, the better option would be to convey a cat and grow it in your house. When the mouse hears the ‘mew’ noise of cat, it will evade away to some far off places. The cats are the actual terrible scenarios for the mice. Having a cat as a pet is safest and cheapest method to eliminate mice. The cat will control the trouble for you and will give you a safer home without rodents.
2. By the use of snap trap
In the snap trap, you could be successful in eliminating one or two mice. But after that, you are not able to get them to it. Some people say that the reason for this is, when the mouse dies, it leaves a sort of smell in the iron bars. This smell generates other mice cautious, and so they stay away from them.
3. Use of mouse cages
Some make use of mouse cages to get rid of mice. In this cage, the mouse fascinated by the bait placed goes inside, and the trap closes. Any group of mice can run a search on the same way. It acts based on one-way mechanism. The mouse can solely enter into it and cannot come out. After going in, they can eat the bait placed inside of. After eating, they will try to find a way out but in vain. This is one of many methods to get rid of mice. You can capture more than one mouse at a time and release them at a far off place.
Conclusion
 You have to get rid of mice to be certain your safety and there are humane mouse traps available. No matter if you follow a humane method or inhumane method is not talked about here. Your safety is very essential. If you do not check the mice at home, their population will raise incredibly, and they will carry disease causing germs.…
You have to get rid of mice to be certain your safety and there are humane mouse traps available. No matter if you follow a humane method or inhumane method is not talked about here. Your safety is very essential. If you do not check the mice at home, their population will raise incredibly, and they will carry disease causing germs.…
How To Find A Good Roofing Contractor
When it comes to finding a roofing contractor for your house, you need to make sure that you find the right one. This is because failing to do so, may lead to serious problems shortly. With lots of roofing contractors in the industry, achieving this task may prove to be a bit challenging. However, with the right information and will, you can find a good roofing contractor that will be able to give you the perfect services. This article provides you with the things that you need to put into considerations if you are to find the right roofing contractor.
Reputation
 When looking for a roofing company, it is good to ensure that you find a contractor with a good reputation. A good roofing company will always strive to make sure that their clients are well satisfied. This, therefore, will imply that they will always do a good job. But how do you find a company with a good reputation? Well, it is very simple. All that you need is to talk to those people who have, already used the company’s services. You can also know the reputation of a roofing company by reading its online reviews. A good roofing company will always have many positive reviews.
When looking for a roofing company, it is good to ensure that you find a contractor with a good reputation. A good roofing company will always strive to make sure that their clients are well satisfied. This, therefore, will imply that they will always do a good job. But how do you find a company with a good reputation? Well, it is very simple. All that you need is to talk to those people who have, already used the company’s services. You can also know the reputation of a roofing company by reading its online reviews. A good roofing company will always have many positive reviews.
Attitude
Since you will be working with the roofing company for a good while, it is good to find a company that you will be comfortable to work with it. This means that you will have a good relationship with the contractor and this is critical as it will enhance the communication with the company. This can only be possible if the company that you walk with is transparent and willing to ensure that its clients are satisfied.
Licensed
Ensuring that you find a good a licensed roofing contractor need to be given the priority. This is a sure proof that the company can deliver good work. It is also a sure way of being sure that you will get the value of your money since the roofing contractor will do a good job. Remember that in some states, it is a requirement that you’re roofing contractors to hold a valid license from the relevant authority.
Do they offer a warranty?
 Another important that you also need to look at when looking for a roofing contractor is that if they offer a warranty. Perfect contractors will always offer a warranty to their clients. This is because they trust the work of their hands and they know that roofs installed by them are there to stay.…
Another important that you also need to look at when looking for a roofing contractor is that if they offer a warranty. Perfect contractors will always offer a warranty to their clients. This is because they trust the work of their hands and they know that roofs installed by them are there to stay.…
What you need to know about investing in a condo
For anyone finding themselves asking the question of what is a condo, learning more about this unique real estate option and what it has to offer can give them a chance to make use of all the advantages it has to offer. If you are interested in owning a residence that gives you all the advances and conveniences you would find in a rented apartment along with all the value you find by owning your property outright, this might be the option for you. Those who would ask themselves what is a condo good for may find a world of value in the answer.
Regarding a Real Estate Investment
 A condo can offer the same investment advantages as you would find in a conventional home, only with a more convenient location, less worries regarding landscape and lawn care upkeep as well as any advantages you might expect to find experience rented apartment. Condos can make ideal investment properties precisely because they offer so little regarding upkeep and maintenance costs when compared to a home. Considering Grandeur park residences for your next investment property may be a smart move financially.
A condo can offer the same investment advantages as you would find in a conventional home, only with a more convenient location, less worries regarding landscape and lawn care upkeep as well as any advantages you might expect to find experience rented apartment. Condos can make ideal investment properties precisely because they offer so little regarding upkeep and maintenance costs when compared to a home. Considering Grandeur park residences for your next investment property may be a smart move financially.
Regarding Price
Depending on location, condominiums can go for much less than a home in the surrounding neighborhood. Additionally, properties that are located more centrally and have greater ease of access to the city may fetch far higher prices per square foot than you might expect. Finding a condo option that fits your lifestyle as well as your budget is the chance to own the home you have always dreamed of, as well as making a valuable investment in your financial future.
Finding the Right Condo for Your needs
By asking what is a condo that meets all of my needs, you can be begin outlining your search. Finding a housing option that can give you all of the conveniences of modern urban living, every advantage you would expect to find when living in a comparable apartment community as well as the chance to enjoy a valuable real estate investment and the asset may be the opportunity to enjoy a superior way to live.
For anyone who would ask themselves what a condo is, the answer is a convenience, affordable and the chance to make the most out of any urban living opportunity or investment.
Condos are less expensive to maintain than detached homes due to the most stable nature of ongoing costs of ownership.…
Finding a House That Meets Your Needs
Becoming a home owner is a big achievement. To find your dream house, you need to look at SKN Listings for the different options. Besides the type, size and price range of the house of your choice, there are other crucial factors you need to consider to find a house that suits your needs.
Factors to consider
According to the above research, a large percentage of people across all generations purchased their home through agents. Only 5% of the elderly bought directly from the homes’ previous. Whether you choose to do your home search online or through agents, consider the following points to avoid future regrets.
Safety
This should come first on your list of things to consider. Houses in neighborhoods that have a high rate of crime come cheap compared to houses in secure areas. If it is too cheap, think twice.
Geographical Location
This is very important especially if you plan to stay in your new home for a long time. How close is this home to your workplace? Are there employment opportunities in the area? How far or close is it to your loved ones? Does the general lifestyle in this area come close to yours? If the answer is no to all these questions, it’s time to consider another location.
Stay away from Pushy Agents
Gone are the days when agents used to push home buyers to make an offer right away. Make an offer only after you check out different homes, make comparisons and are confident that you are picking the best house. If your agent is pushy, find another one.
School District
This is very important for parents and parents to be. Living in an area that has public schools will save you lots of money compared to living where there are only private schools. Go to each school and find out everything about them. From prices, the size of classes to the percentage of students admitted to college, etc.
Don’t Trust Everything Ads Say
Advertisements are made with the interests of the seller in mind, not the buyers. Most leave out important information such as repairs needed, power lines, etc. This is why you should have an agent who will assess the house and ensure it meets all your needs before you make an offer.
For previous homeowners, make sure you sell your house first before buying a new one. Contingency sales will cost you a lot more, probably thousands of dollars. Give careful consideration to the above points and you will be on your way to the best home you will ever own.…
Top Qualities of A Commercial HVAC Provider
Ensuring excellent quality control of your company’s HVAC system is one of the most important things a business investor or the unit manager faces during their daily routine. It may not be possible to inspect the heating or cooling system in the premises every day, yet we still expect them to perform flawlessly and keep all the intended areas like offices, labs and showrooms clean and comfortable. When faults and breakdowns in such system threaten the productivity of your employees and even your overall profits, you must ensure repairs are done promptly. That said, if you plan to install a new system be sure to strike a deal with hvac contractors san diego ca. It is crucial you make some considerations as indicated below however.
Qualities of a commercial HVAC provider
Experience.
How long has the company you are researching been in business? Are they a visible company in the community, and recommended by other businesses and the BBB? Research their reputation on the Internet and through business, contacts to get a clear picture of the people who will handle your workplace HVAC equipment.

Reliability
A good commercial HVAC operation should make themselves available to you when emergencies arise, regardless of the time of day or night. Repairmen will arrive on site promptly and make repairs efficiently and without interrupting your regular workflow.
Equipment
What sort of HVAC equipment does the company recommend and install? A reputable provider is often aligned with a trusted name in the industry, and if you are familiar with a specific brand of heating and cooling equipment, you may feel more comfortable working with people approved by that brand.
Eco-Minded
How environmentally friendly is the company you are researching? Do they offer alternatives in HVAC operations that can reduce your carbon footprint while maintaining high energy efficiency? In the long term, you want to save money and keep a reasonable budget for your power plant. A reputable commercial HVAC company will help you.
Cost
Shop around for the best estimate. If you feel an HVAC company is trying to sell you more equipment than you need, you may wish to seek a second estimate for services. A professional HVAC provider is concerned for your welfare and the comfort of those working under you while building their reputation for excellent service.

Seek referrals within your community for the best possible commercial HVAC contractor to provide the tools you needs to maintain a functional and productive work environment.…
Purchasing A Car Vacuum Cleaner; Things To Consider

Nowadays, a vacuum cleaner is utilized for much more than just cleaning floors and, it can be applied for some purposes such as cleaning furniture, cars, and shampooing carpets. You need a vacuum cleaner to clean your car. You should buy one if you don’t have it. The following are the things to consider for you to get the right vacuum.
Type Of Vacuum
Wall-Mount and cordless are the two types of vacuum cleaners in the market. The wall-mount units render the powerful suction power, but they are restricted by the size of the place that they can reach. Cordless vacuums operate on rechargeable batteries are smaller, and are simple to carry around. Their main imperfection is that they don’t have a great suction power. You should consider the pros and cons of each type and decide on the one that works better for you.
Size Of Your Car
It is important to consider the size of the vehicle when choosing a vacuum cleaner. Cars come in various designs and sizes. Don’t buy a small vacuum if you have a big car as you will struggle and become tired when cleaning the car just invest in a large vacuum to simplify your work. On the other hand, a great cleaner won’t be ideal if you have a small car as it may not be able to fit in the limited space.
Reach Of The Cleaner
To quickly get rid of debris and dirt from your car, go for a unit with the capacity to reach all sections of the car. This calls for you to spend in a unit with larger hoses and more attachments. Go with groups with ergonomic designs when making the purchase as they are not only easy to use, they also serve for a long time.
Ease To use
Having a great cleaner is of no use if it’s hard to use. To have an easy time go for a unit that is simple to use and detach. While it’s advised that you wash your car, your kid should also be capable of connecting the unit to a power source and cleaning the car. Avoid a vacuum cleaner that is complicated to use.
Apart from considering the ease of handling a vacuum cleaner, also weigh the ease of maintenance. Replace or maintain the worn out parts just like any other unit in your house. The unit that you are getting should have simple-to-find components.…
When To Use An Expert For Garage Door Repair

In your home, a garage door is one of the most vital components in various ways. It a means to express the individuality of your property provides the entryway to your house as it is one of the forward facings aspects of your house. As your treat, the house door importantly and maintained the garage door should also be treated the same.
Garage doors normal begin to show signs of malfunctioning over time. It could be the whole door needs a mechanism or something easy as replacing a spring. The issue with the garage door is that you can’t tell about its problem until it is too late. Then you are bound with either hiring an expert for tasks that are too challenging for you to undertake or just do the repair by yourself.
Common Difficulties You May Face With The Door
Several common issues arise with electronic garage doors. Some of them are a simple fix while others need the help of a skilled practitioner to come and assist you in correcting the problem.
Remote Door Opener Stops Functioning
It is a sign that you may require having your battery replaced. It is first thing to try, before any other solution, as it is the least costly to fix. If changing the battery does not assist the remote opener to begin working again, it can be a problem due to programming. Remotes are programmed to their particular doors and the devices that lie within. It an indication that the mechanism is failing if the remote opener is failing to operate in some cases. You can change the battery yourself, but a repair professional must address the programming and device failure of the garage door.
Garage Door Fails To Open
Several times when this occurs; it is as a result of a buildup in the door itself. Whether it is a mixture of grass, leaves, or dirt, it can grow into the mechanism and clog it. An expert can extract this buildup and repair your door to working condition. If it is not a buildup, the reasonable explanation, then, is that spring has broken due to the tremendous tension that they have during the life of your usage. Spring replacements should be done by a qualified specialist who is proficient in garage door repair.
Garage doors are electric devices that are subjected to fair daily use so it reasonable for them to show symptoms of malfunction. It is better to know when you require an expert to repair it or when you can just do it by yourself.…


 Professional Services
Professional Services




 Cost
Cost


